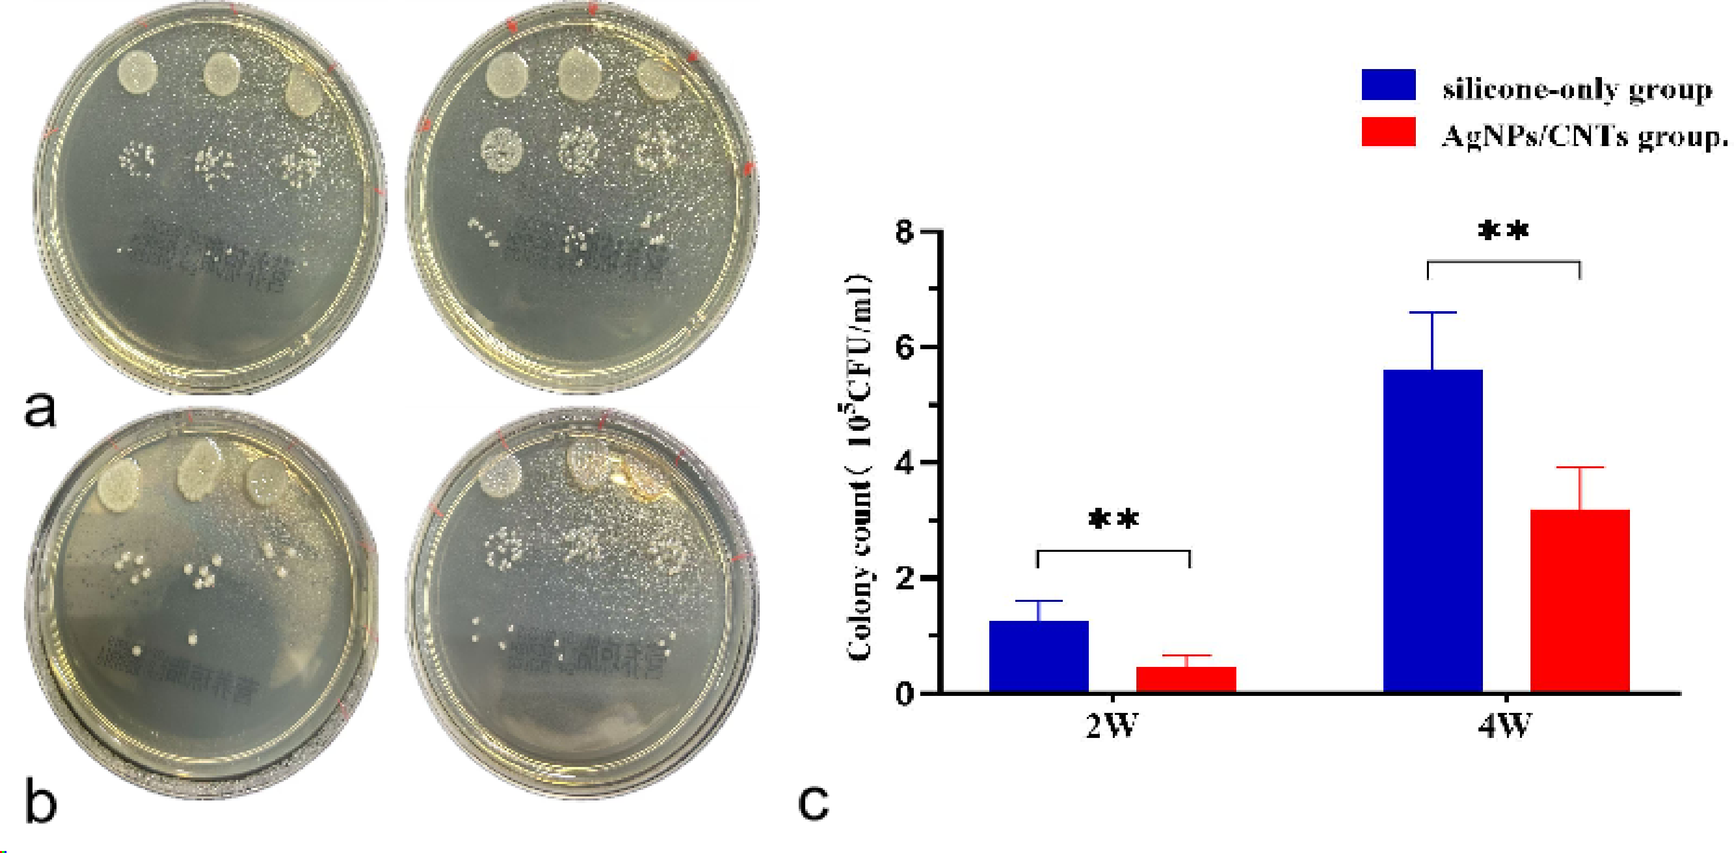
Fig. 4

Fig. 4
Colony culture and statistical comparison after tracheal stent implantation. (a) Plate colony formation images after ordinary silicone stent implantation in the trachea for 2 weeks and 4 weeks; (b) Plate colony formation images after AgNPs/CNTs-coated stent implantation in the trachea for 2 weeks and 4 weeks, showing that the number of colonies gradually increases with the duration of stent implantation;(c) Statistical comparison of colony numbers after 2 weeks and 4 weeks of stent implantation in the two groups. Note Dilution gradient to 10−3, *P < 0.05 and **P < 0.005.
